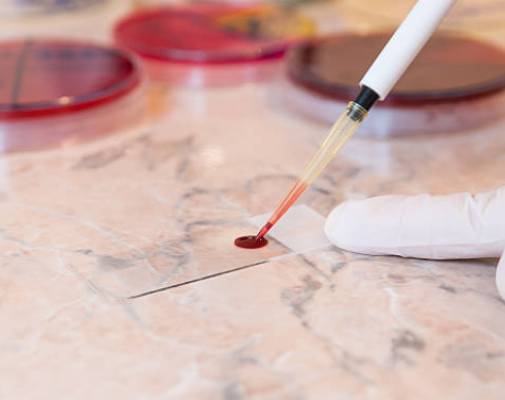
service

GRH Health Care Clinic and Diagnostics is committed to delivering compassionate, affordable, and accessible healthcare to individuals and families across Pallipattu and surrounding areas.
We specialize in Primary Health Care Services that address all common medical needs, supported by personalized care plans. Our team provides expert treatment for Diabetes and Hypertension, aiming to manage, control, and improve patient outcomes through continuous monitoring and education.
Understanding the unique needs of elderly patients, we offer dedicated Geriatric Care Services to ensure comfort, safety, and proactive health management for senior citizens.
Our Diagnostics and Lab Services include advanced pathology, blood testing, ECG, and preventive screening — all managed with precision and timely reporting.
At GRH, we believe in a whole-patient approach, offering not just treatment, but lifestyle guidance, disease prevention advice, and specialized health packages to support your wellness journey.

At GRH Health Care Clinic & Diagnostics, we deliver compassionate and affordable healthcare. With our experienced team and advanced diagnostics, your well-being is always in trusted hands.
FBS, PPBS, HbA1c, Lipid Profile, Blood Urea, Serum Creatinine, eGFR, Complete Urine Analysis
Comprehensive screening to monitor and manage blood sugar levels effectively.
CBC, FBS, PPBS, Sr.Creatinine, T.Cholestrol, T.Bilirubin, Urine Analysis, ECG, BP, BMI, WHR, WC
CBC, FBS, PPBS, Lipid Profile, Liver Function Test, Blood Urea, Sr. Creatinine, eGFR, TSH, Complete Urine Analysis, ECG, BP, BMI, WHR, WC
A full-body screening package designed to assess overall health and detect early signs of illness.
Get in touch with us.
33, West Street, Pallipattu
Thiruvallur - 631207
Tamilnadu